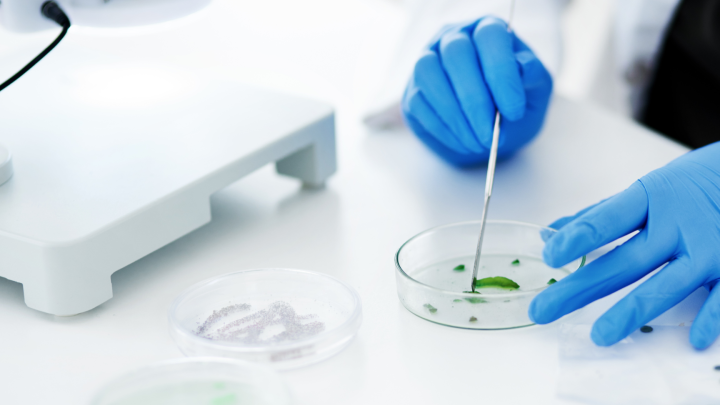

私たちは日々、様々な製品を選ぶ際にその成分が気になりますよね。特に化粧品や食品においては、健康や美容に直結するため、成分調査の重要性はますます高まっています。成分調査は、私たちが安全で効果的な製品を選ぶための鍵です。
成分調査の重要性
成分調査は、私たちが選ぶ製品の安全性と効果を理解するための不可欠なステップです。特に化粧品や食品の場合、成分が健康や美容に直接影響することがあります。そのため、以下の理由から成分調査が重要です。
- 安全性の確認: 多くの製品には、アレルギーを引き起こす可能性がある成分が含まれていることがあります。成分調査により、危険な成分を避けることができます。
- 効果の理解: 特定の成分が肌や体に与える効果を知ることで、適切な製品選びが可能になります。例えば、抗酸化物質が含まれている化粧品は、肌の老化を防ぐ効果があります。
- トレーサビリティ: 成分の出所や製造過程を把握することで、倫理的かつ持続可能な選択ができるようになります。例えば、オーガニック成分が使われている製品は、環境に優しい選択肢です。
- 消費者権利の保護: 製品に関する正確な情報を得ることで、消費者として自分たちの権利を守ることが可能になります。不正確な表記や隠された成分に対して敏感でいるべきです。
成分調査の方法
成分調査は、安全性や効果を確認する重要な手段です。具体的な手法に従って、詳細に調査を行います。
ラボテストの手順
ラボテストは、成分を正確に分析するためのプロセスです。以下の手順で進めます。
- サンプルの収集: 調査対象の製品から成分サンプルを取り出します。
- 前処理: サンプルを適切なサイズに加工し、テスト準備を整えます。
- 分析実施: 高度な分析機器を用いて成分を測定し、結果を記録します。
- データ解析: 得られたデータを基に各成分の濃度や構成を検討します。
このプロセスによって、正確な成分情報が得られます。
分析機器の種類
成分調査には様々な分析機器が用いられます。以下の機器が特に一般的です。
- ガスクロマトグラフ: 揮発性成分の分離・定量を行います。
- 液体クロマトグラフ: 非揮発性成分を分析し、混合物の詳細を明らかにします。
- 質量分析計: molecular weightを測定し、化合物の構造を特定します。
- 赤外分光分析計: 成分の化学的特性を理解するために利用されます。
成分調査の事例
成分調査は日常的に私たちの健康や美容に影響を与える重要な手段です。このセクションでは、化粧品と食品における成分調査の具体例を挙げます。
化粧品の成分分析
化粧品の成分分析は、私たちの肌に直接影響を与えるため、特に重要です。以下に、化粧品成分調査の主なポイントを示します。
- ラボ検査: サンプルの収集から始まり、厳密な前処理を行った後、分析が実施されます。
- 成分の安全性: アレルギーを引き起こす可能性のある成分を特定します。
- 効果の確認: 特定の成分が肌に与える影響を評価します。実際に、ビタミンCやヒアルロン酸の効果が研究されています。
- 最新の技術: ガスクロマトグラフや質量分析計などの機器を用います。これにより、成分の正確な情報を得られます。
これらの方法を使うことで、安全で効果的な化粧品選びが可能になります。
食品の成分検査
食品の成分検査も私たちの健康を守る大切なプロセスです。以下の点が特に重要です。
- 成分リストの確認: 食品パッケージに記載されている成分リストの内容が確認されます。
- アレルゲンの特定: 小麦やナッツなどのアレルゲンの有無を検査します。
- 栄養価の評価: 食品に含まれるビタミンやミネラルの量を測定します。例えば、カルシウムや鉄分の含有量が重要です。
- 微生物検査: 食品の衛生状態を確認し、有害な微生物が含まれていないかを確かめます。
成分調査の法規制
私たちが製品の成分調査を行う際、法規制は非常に重要です。特に、化粧品や食品に関する規制は消費者を保護するために設けられています。
- 化粧品の規制: 日本では、化粧品に関する法令は、主に「薬事法」に基づいています。この法律により、製品の成分や表示が厳格に管理されています。
- 食品の規制: 食品業界では、「食品衛生法」が適用され、食品の成分表示や安全性が確保されています。栄養成分やアレルゲンの表示が義務付けられています。
また、これらの法規制は、製品の安全性や効果を保証するために不可欠です。成分に関する情報が正確であることは、消費者に安心感を与えます。さらに、製品が不適切な成分を含んでいる場合には、迅速に市場から撤去され、消費者の健康が守られる仕組みが整っています。
国際的な法規制も考慮する必要があります。私たちが海外製品を選ぶ際、欧州連合(EU)やアメリカ合衆国の規制による影響が大きくなります。例えば、EUでは化粧品に使用できる成分がリスト化されており、安全基準が設定されています。したがって、各国の法律を理解することは、私たちの製品選びや成分調査において重要です。
今後の展望
成分調査の今後には、いくつかの重要な展望が存在します。まず、テクノロジーの進化が成分分析を加速させる。高性能な分析機器が登場することにより、より迅速かつ正確な成分の特定が可能になるでしょう。
また、消費者の意識向上が影響を与える。人々が健康や環境に配慮した商品を選ぶ傾向が強まりつつある中、透明性を求める声が高まります。透明性のある情報提供が企業に求められるため、消費者の信頼を獲得するための重要な要素となります。
さらに、国際的な規制の変化も注目すべき点です。新しい法規制が施行されるおそれがあり、特に環境基準に関しては厳しくなる可能性があります。企業は、新たなルールに対応できるように柔軟に戦略を見直す必要があります。
また、市場のニーズに応じた成分選定も重要です。異なる地域や文化、ライフスタイルに基づいた製品開発が進む中、私たちは多様な成分調査が求められる状況に直面しています。ニーズに基づいた製品を提供できる企業が優位に立つでしょう。
最後に、持続可能性の観点も無視できません。環境に優しい成分やパッケージの選定が、企業にとっての責任となりつつあります。私たち自身も、より持続可能な製品を支持することで、業界全体の意識を高めることが可能です。
Conclusion
成分調査は私たちの健康や美容に直結する重要なプロセスです。私たちが選ぶ製品の成分を理解することで安全性や効果を確認し、より良い選択ができるようになります。テクノロジーの進化により成分分析が進化しつつある今、透明性のある情報提供が企業に求められる時代が来ています。
消費者としての私たちの意識も変わりつつあり、倫理的で持続可能な選択を重視することが求められています。成分調査を通じて、私たち自身の健康を守りつつ、信頼できる製品を選ぶ力を育てていきましょう。